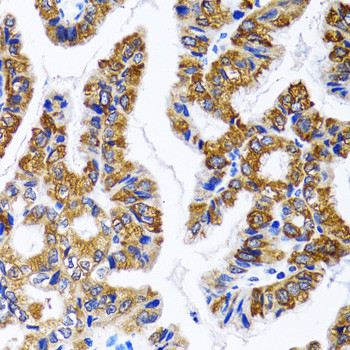
FASN Antibody in Immunohistochemistry (Paraffin) (IHC (P))

Search
Invitrogen
FASN Polyclonal Antibody
{{$productOrderCtrl.translations['antibody.pdp.commerceCard.promotion.promotions']}}
{{$productOrderCtrl.translations['antibody.pdp.commerceCard.promotion.viewpromo']}}
{{$productOrderCtrl.translations['antibody.pdp.commerceCard.promotion.promocode']}}: {{promo.promoCode}} {{promo.promoTitle}} {{promo.promoDescription}}. {{$productOrderCtrl.translations['antibody.pdp.commerceCard.promotion.learnmore']}}
图: 1 / 5
FASN Antibody (PA5-87440) in IHC (P)





Please note: We are reviewing Western blot images included in the antibody testing data in our catalog, including those provided by third parties. Unless expressly labeled or annotated as “raw-unedited”, Western blot images included in the antibody testing data in our catalog may have been edited, optimized or otherwise adjusted for presentation.
产品信息
PA5-87440
种属反应
宿主/亚型
分类
类型
抗原
偶联物
形式
浓度
规格
纯化类型
保存液
内含物
保存条件
运输条件
RRID
产品详细信息
Immunogen sequence: QQQTQLNLRS LLVNPEGPTL MRLNSVQSSE RPLFLVHPIE GSTTVFHSLA SRLSIPTYGL QCTRAAPLDS IHSLAAYYID CIRQVQPEGP YRVAGYSYGA CVAFEMCSQL QAQQSPAPTH NSLFLFDGSP TYVLAYTQSY RAKLTPGCEA EAETEAICFF VQQFTDMEHN RVLEALLPLK GLEERVAAAV DLIIKSHQGL DRQELSFAAR SFYYKLRAAE QYTPKAKYHG NVMLLRAKTG GAYGEDLGAD YNLSQVCDGK VSVHVIEGDH RTLLEGSGLE SIISIIHSSL AEPRVSVREG; Positive Samples: H460; Cellular Location: Cytoplasm, Melanosome
靶标信息
Fatty acid synthase is a multifunctional protein. Its main function is to catalyze the synthesis of palmitate from acetyl-CoA and malonyl-CoA, in the presence of NADPH, into long-chain saturated fatty acids. In some cancer cell lines, this protein has been found to be fused with estrogen receptor-alpha (ER-alpha), in which the N-terminus of FAS is fused in-frame with the C-terminus of ER-alpha.
仅用于科研。不用于诊断过程。未经明确授权不得转售。
篇参考文献 (0)
生物信息学
蛋白别名: 3-hydroxyacyl-[acyl-carrier-protein] dehydratase; 3-oxoacyl-[acyl-carrier-protein] reductase; 3-oxoacyl-[acyl-carrier-protein] synthase; [Acyl-carrier-protein] S-acetyltransferase; [Acyl-carrier-protein] S-malonyltransferase; Acyl-[acyl-carrier-protein] hydrolase; encodes region of fatty acid synthase activity; FAS; multifunctional protein; Enoyl-[acyl-carrier-protein] reductase; FAS; Fatty acid synthase; MGC14367; MGC15706; short chain dehydrogenase/reductase family 27X, member 1; Type I fatty acid synthase
基因别名: FAS; FASN; OA-519; SDR27X1
Entrez Gene ID: (Human) 2194